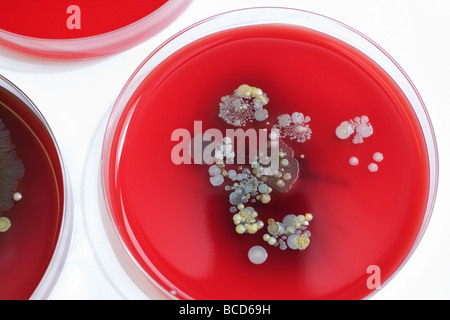
Staphylococcus Epidermidis Temperature In Incubator: Lab Guidelines

Sibling relationships are often the longest-lasting bonds we form in life, spanning childhood, adolescence, and adulthood. However, maintaining healthy and harmonious connections with our brothers and sisters can be challenging, given the complex dynamics and shared history that come with familial ties. In this article, we explore five expert-backed strategies to foster positive and supportive sibling relationships, offering insights and practical advice for navigating the unique terrain of familial bonds. As we delve into these tips, we'll uncover the keys to building enduring connections that nurture both personal growth and familial unity, backed by psychological research and the wisdom of family dynamics experts.,sibling relationships,family bonds,healthy connections
Understanding the Complex Dynamics of Sibling Bonds
Before delving into the strategies for fostering healthy sibling relationships, it’s crucial to grasp the intricate nature of these bonds. Sibling relationships are unique, shaped by shared experiences, competing needs, and the ever-evolving dynamics of family life. Unlike friendships, which we choose, sibling relationships are involuntary and often lifelong, making them a complex tapestry of emotions, memories, and shared histories. Understanding this complexity is the first step towards navigating these relationships with empathy and awareness.,sibling dynamics,shared experiences,empathy
The Role of Birth Order and Personality Traits
Birth order can significantly influence sibling relationships. Firstborns, for instance, often assume leadership roles and may feel a greater sense of responsibility. Middle children might feel caught between competing needs, while youngest siblings may be more outgoing and less inhibited. These inherent differences can shape how siblings interact and perceive each other. Additionally, individual personality traits—such as extroversion, neuroticism, or agreeableness—further add layers to these complex dynamics. Recognizing and respecting these unique traits is vital for fostering healthy relationships.,birth order,personality traits,individual differences
For instance, consider a case study where an oldest sibling, driven by a sense of responsibility, takes on a protective role towards their younger sister. While this can be a positive dynamic, it might also lead to the younger sibling feeling smothered or less capable. Recognizing this dynamic and finding a balance between support and independence can be crucial for their individual growth and the health of their relationship.,case study,oldest sibling,protective role
| Birth Order | Common Traits |
|---|---|
| Firstborn | Leadership, responsibility |
| Middle | Mediation, adaptability |
| Youngest | Outgoing, carefree |
Tip 1: Communicate Openly and Honestly
Effective communication is the cornerstone of any healthy relationship, and sibling bonds are no exception. Open and honest dialogue allows siblings to express their feelings, needs, and concerns, fostering understanding and empathy. Here are some strategies for improving communication within sibling relationships.,communication strategies,empathy,understanding
- Schedule regular one-on-one time: Carve out dedicated time to connect with each sibling individually. This provides a safe space for open conversation and allows for deeper, more personal connections.
- Practice active listening: When your sibling is speaking, give them your undivided attention. Repeat back what they've said to ensure understanding and show that you're fully present.
- Use "I" statements: Expressing oneself using "I" statements can help prevent the other person from feeling attacked. For example, "I feel hurt when you make those comments" instead of "You always make me feel bad."
- Be receptive to feedback: Create an environment where both parties feel comfortable providing and receiving constructive feedback. This can help identify areas for improvement and strengthen the relationship.
In the context of sibling relationships, effective communication can resolve conflicts, build trust, and deepen the bond. For instance, consider a scenario where two siblings, despite their differences, make a conscious effort to communicate openly about their feelings and experiences. Over time, this leads to a stronger, more supportive relationship, where they feel comfortable sharing both their joys and struggles.,effective communication,conflict resolution,trust-building
Navigating Conflict with Respect and Empathy
Conflict is an inevitable part of any relationship, including those between siblings. However, how we navigate and resolve these conflicts can make all the difference. Here are some tips for handling disagreements with respect and empathy:,conflict resolution,respect,empathy
- Cool off before addressing the issue: If emotions are running high, take some time to calm down before discussing the conflict. This allows for a more rational and constructive conversation.
- Focus on the issue, not the person: Separate the problem from the individual. Avoid personal attacks and instead, address the specific behavior or issue at hand.
- Find common ground: Look for areas of agreement or shared goals. This can help shift the focus from the conflict to finding a solution together.
- Practice forgiveness: Holding onto grudges can poison sibling relationships. Learn to forgive and move forward, focusing on the positive aspects of your bond.
By approaching conflicts with respect and empathy, siblings can not only resolve issues but also strengthen their relationship. For instance, two siblings who disagree on a particular topic might find common ground by discussing their shared values and goals. This approach not only resolves the immediate conflict but also fosters a deeper understanding and connection.,conflict management,forgiveness,understanding
Tip 2: Foster Mutual Respect and Appreciation
Mutual respect and appreciation are vital components of healthy sibling relationships. Acknowledging and valuing each other’s unique strengths, talents, and perspectives can create a foundation of support and encouragement. Here are some ways to foster this sense of respect and appreciation:,mutual respect,appreciation,support
- Celebrate each other's achievements: Whether it's a promotion at work, a personal milestone, or a creative endeavor, take the time to celebrate your sibling's achievements. This shows support and acknowledges their hard work and dedication.
- Encourage individual pursuits: Respect and encourage each other's unique interests and passions. Attend your sibling's concerts, games, or exhibitions to show your support and interest in their pursuits.
- Offer constructive feedback: Provide honest and constructive feedback when asked. This shows that you value your sibling's growth and development and are willing to help them improve.
- Practice empathy: Try to understand your sibling's perspective, even if you don't agree with it. This demonstrates respect for their thoughts and feelings and can foster deeper understanding.
Fostering mutual respect and appreciation can lead to a stronger, more supportive sibling relationship. For instance, siblings who actively celebrate each other's successes and support their individual pursuits may find that they not only enhance their bond but also inspire and motivate each other to reach new heights.,celebrating successes,supporting pursuits,motivation
The Power of Positive Reinforcement
Positive reinforcement is a powerful tool for strengthening sibling relationships. Recognizing and praising each other’s positive traits and behaviors can create a cycle of encouragement and support. Here’s how you can implement positive reinforcement:,positive reinforcement,encouragement,support
- Notice and acknowledge positive behaviors: Pay attention to the little things your sibling does that demonstrate their love, care, or support. Acknowledging these actions can encourage them to continue such behaviors.
- Offer specific praise: Instead of general compliments, provide specific praise that highlights the exact behavior or trait you appreciate. For example, "I really admire your patience with our younger brother. It's a quality I strive to emulate."
- Use non-verbal cues: Sometimes, a simple smile, a pat on the back, or a hug can speak volumes. These non-verbal cues can reinforce positive behaviors and strengthen your bond.
- Encourage and celebrate growth: As your siblings grow and develop, celebrate their progress and milestones. This can include everything from learning a new skill to overcoming a personal challenge.
By using positive reinforcement, siblings can create a supportive environment that nurtures their individual growth and strengthens their relationship. For instance, a sibling who consistently acknowledges and praises their brother's efforts in a new hobby might inspire him to continue pursuing it, leading to personal growth and a deeper connection.,acknowledgement,praise,growth
Tip 3: Set Boundaries and Respect Privacy
Setting boundaries and respecting privacy are essential aspects of healthy sibling relationships. While siblings share a unique bond, they also have a right to their own space, thoughts, and feelings. Here’s how to navigate this delicate balance:,boundary setting,privacy,individual space
- Define personal boundaries: Discuss and respect each other's boundaries. This could include physical space, personal belongings, or even emotional boundaries, such as respecting each other's need for alone time or personal opinions.
- Respect privacy: Avoid invading each other's privacy without permission. This includes respecting personal journals, electronics, or private conversations.
- Communicate about boundaries: If a boundary is crossed, communicate openly about it. Explain how it made you feel and discuss ways to prevent it from happening again.
- Understand the need for alone time: Everyone needs some alone time to recharge. Respect your sibling's need for solitude and use this time to reflect on your own thoughts and feelings.
Setting boundaries and respecting privacy can enhance the trust and respect within sibling relationships. For instance, two siblings who consistently respect each other's personal space and privacy may find that they have a deeper, more authentic connection. This understanding allows for a safe and supportive environment where each individual can thrive.,trust,authenticity,personal space
Managing Conflict Over Shared Spaces
Conflict over shared spaces is a common challenge in sibling relationships, especially in close-knit families. Here are some strategies for managing these situations:,conflict management,shared spaces,cooperation
- Establish shared space rules: Discuss and agree upon rules for shared spaces, such as common areas or shared rooms. This could include rules about cleanliness, noise levels, or personal space.
- Rotate personal spaces: If possible, rotate personal spaces or assign specific days for individual use of shared rooms. This can provide each sibling with their own space while also fostering a sense of equality.
- Collaborate on organization: Work together to organize shared spaces in a way that accommodates everyone's needs. This can involve finding creative storage solutions or establishing designated areas for personal belongings.
- Practice compromise: In situations where conflicts arise over shared spaces, practice compromise. This could mean finding a middle ground or taking turns to ensure everyone's needs are met.
By managing shared spaces cooperatively, siblings can minimize conflict and foster a sense of unity. For instance, two siblings who collaboratively organize their shared room might find that they not only have a more functional space but also a stronger bond through their shared effort.,cooperative organization,conflict minimization,unity
Tip 4: Create Shared Traditions and Memories
Creating shared traditions and memories is a powerful way to strengthen sibling bonds. These shared experiences can create a sense of belonging and foster a unique, unbreakable connection. Here are some ideas for building these shared moments:,shared traditions,memories,belonging
- Family vacations: Plan annual family vacations that include all siblings. These trips can create lasting memories and provide a shared experience that strengthens familial bonds.
- Holiday traditions: Establish unique holiday traditions that involve all siblings. Whether it's a special meal, a gift exchange, or a family game, these traditions can become cherished memories.
- Siblings-only outings: Plan outings or activities that are exclusive to siblings. This could be a weekly movie night, a sports game, or a hike. These activities provide dedicated time for sibling bonding.
- Create family rituals: Establish simple rituals, such as a weekly family dinner or a Sunday morning walk. These rituals provide a consistent opportunity for connection and can become cherished family traditions.
Shared traditions and memories can create a strong foundation for sibling relationships. For instance, siblings who have shared annual vacations might look back on these trips as a source of joy and connection, even as they grow older and their lives take different paths.,family vacations,holiday traditions,shared experiences
The Impact of Shared Experiences
Shared experiences play a pivotal role in shaping sibling relationships. These experiences create a shared history and a unique bond that can withstand the test of time. Here’s how shared experiences can enhance sibling connections:,shared history,unique bond,lasting impact
- Creating a shared identity: Shared experiences help to forge a unique, shared identity among siblings. This identity can provide a sense of belonging and strengthen the sibling bond.
- Building empathy and understanding: Going through similar experiences can foster empathy and understanding between siblings. This shared perspective can lead to deeper connections.
- Providing a foundation for future relationships: The memories and connections formed through shared experiences can serve as a foundation for future relationships. Siblings who have shared positive experiences are more likely to maintain a strong bond as they navigate life's challenges.
For example, siblings who have grown up participating in the same extracurricular activities might develop a shared passion and a deep understanding of each other's strengths and challenges. This shared experience can form the basis of a strong, supportive relationship that lasts a lifetime.,shared identity,empathy,future relationships
Tip 5: Support Each Other’s Growth and Development
Supporting each other’s growth and development is a key aspect of healthy sibling relationships. As siblings, we have a unique opportunity to encourage and inspire each other’s personal journeys. Here’s how to nurture this aspect of your sibling bond:,growth support,inspiration,personal journeys
- Offer encouragement: Provide words of encouragement and support as your siblings pursue their goals and dreams. This can help boost their confidence and motivation.
- Share resources: If you come across resources, such as books, articles, or workshops, that could benefit your sibling's growth, share them. This shows your investment in their development.
- Be a sounding board: Offer a listening ear and provide constructive feedback when your sibling needs to bounce ideas off someone. This can help them clarify their thoughts and make informed decisions.
- Celebrate milestones: Mark important milestones in your sibling's life, such as graduations, job promotions, or personal achievements. Celebrating these moments shows your support and pride in their accomplishments.
By supporting each other's growth, siblings can foster a sense of camaraderie and mutual encouragement. For instance, a sibling who actively celebrates their brother's achievements and offers support during challenging times might inspire him to pursue his goals with renewed determination. This mutual support can create a powerful dynamic that fuels both individuals' growth.,encouragement,mutual support,camaraderie
Navigating Competitive Dynamics
Competitive dynamics can sometimes arise in sibling relationships, especially when siblings are close in age or have similar interests. While a healthy dose of competition can be motivating, it’s important to manage it constructively. Here’s how to navigate competitive relationships:,competitive dynamics,constructive management,motivation
- Focus on personal growth: Encourage siblings to see competition as a motivator for personal growth rather than a battle for superiority. Emphasize the value of self-improvement and learning from each other.
- Celebrate individual achievements: When one sibling achieves something, celebrate their success without comparing it to the other's accomplishments. This shows respect for their individual journeys and encourages a healthy competitive spirit.
- Encourage collaboration: Instead of always pitting siblings against each other, find opportunities for them to collaborate. This could be through team sports, group projects, or even just joint problem-solving activities.
- Promote healthy rivalry: A little friendly rivalry can be fun and motivating. Encourage siblings to challenge each other in a positive, supportive way, focusing on mutual growth rather than winning at all costs.
By managing competitive dynamics constructively, siblings can turn potential sources of tension into opportunities for growth and connection. For instance, two siblings who engage in friendly competition might find that it drives them both to excel, while also fostering a deeper appreciation for each other's strengths and a stronger bond.,healthy competition,mutual growth,appreciation
How can I repair a damaged sibling relationship?
+Repairing a damaged sibling relationship requires time, effort, and a genuine desire for reconciliation. Start by acknowledging the issue and taking responsibility for your role in the conflict. Initiate open and honest communication, expressing your willingness to work on the relationship. Focus on understanding each other’s perspectives and finding common ground. It may also be helpful to seek mediation from a neutral third party, such as a therapist or trusted family member. Remember, rebuilding trust takes time, so be patient and consistent in your efforts. Eventually, with mutual respect and understanding, you can restore the bond and strengthen your sibling relationship.,reconciliation,open communication,trust-building
What if my sibling doesn’t want to improve our relationship?
+If your sibling is not receptive to improving your relationship, it can be